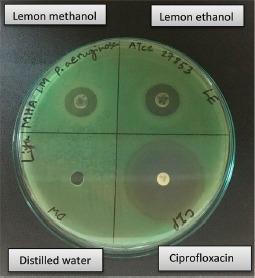
https://cdn.ncbi.nlm.nih.gov/pmc/blobs/0ba9/6186015/68734694184d/eujmi-08-095-g001.jpg

某些商业水果(苹果、木瓜、柠檬和草莓)对引起尿路感染的细菌的抗菌活性测定
Determination of Antimicrobial Activity of Some Commercial Fruit (Apple, Papaya, Lemon and Strawberry) Against Bacteria Causing Urinary Tract Infection.
作者信息
Liya Sabiha Jahan, Siddique Romana
机构信息
Department of Mathematics and Natural Sciences, BRAC University, 66 Mohakhali, Dhaka-1212, Bangladesh.
出版信息
Eur J Microbiol Immunol (Bp). 2018 Aug 16;8(3):95-99. doi: 10.1556/1886.2018.00014. eCollection 2018 Sep 28.
Urinary Tract Infection (UTI) is a worldwide phenomenon in modern times, in which the dependency on antibiotics for its treatment is increasing. The current study was conducted in order to find alternatives to antibiotics by investigating some commercial fruits for their antimicrobial activity. The fruits in this study included green apple (), papaya (), lemon (), and strawberry (), which were used to prepare methanolic and ethanolic extracts through Soxhlet extraction technique. The extracts were used against bacteria that cause UTI, and five different strains were selected: (ATCC: 15922), (ATCC: 25922), (ATCC: 27853), (ATCC: 29212), and . Antimicrobial tests of the extracts were conducted by following the agar well diffusion method, where ciprofloxacin was used as a positive control, and autoclaved distilled water was used as a negative control. Among the fruits, apple and papaya extracts did not show any zone of inhibition against any of the tested bacteria. However, both lemon and strawberry extracts showed inhibition zone against all of the mentioned bacteria. The ethanolic extracts of lemon and strawberry were more potent than their methanolic extracts. Lemon ethanolic extract showed the highest zone of inhibition against (ATCC: 27853) (18.34 ± 0.58) and lowest one against (16.00 ± 1.00). Strawberry ethanolic extracts showed the highest zone of inhibition against (ATCC: 27853) (16.33 ± 0.58) and the lowest one against (13.33 ± 0.58). As antibiotic resistance is paving the way for multi-drug resistant bacteria, the results of lemon and strawberry can be considered to be used as an antimicrobial agent in treating urinary tract infections.
尿路感染(UTI)是现代社会中一种全球普遍存在的现象,其治疗对抗生素的依赖性日益增加。本研究旨在通过调查一些商业水果的抗菌活性来寻找抗生素的替代品。本研究中的水果包括青苹果()、木瓜()、柠檬()和草莓(),通过索氏提取技术制备甲醇提取物和乙醇提取物。这些提取物用于对抗引起尿路感染的细菌,并选择了五种不同的菌株:(美国典型培养物保藏中心:15922)、(美国典型培养物保藏中心:25922)、(美国典型培养物保藏中心:27853)、(美国典型培养物保藏中心:29212)和。提取物的抗菌测试采用琼脂孔扩散法进行,其中环丙沙星用作阳性对照,高压灭菌蒸馏水用作阴性对照。在这些水果中,苹果和木瓜提取物对任何测试细菌均未显示出抑菌圈。然而,柠檬和草莓提取物对所有上述细菌均显示出抑菌圈。柠檬和草莓的乙醇提取物比其甲醇提取物更有效。柠檬乙醇提取物对(美国典型培养物保藏中心:27853)显示出最高抑菌圈(18.34±0.58),对显示出最低抑菌圈(16.00±1.00)。草莓乙醇提取物对(美国典型培养物保藏中心:27853)显示出最高抑菌圈(16.33±0.58),对显示出最低抑菌圈(13.33±0.58)。由于抗生素耐药性正在为多重耐药细菌铺平道路,柠檬和草莓的研究结果可被视为用于治疗尿路感染的抗菌剂。